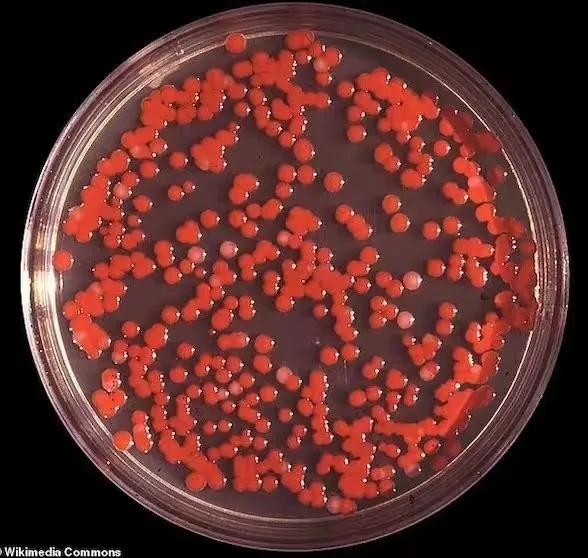

机器人伴侣:满足情感需求还是替代真实伴侣?
2026-01-04 06:10:42
美国这场神秘雾霾,让人陷入“迷雾”之中
近日,美国多地被一片白茫茫的雾霾笼罩,街头巷尾,人们议论纷纷,心头不禁蒙上一层阴影。这究竟是怎么回事呢?

佛罗里达州的David Bamber表示,雾霾让他看不清前方的道路,空气中弥漫着一股刺鼻的化学品味道。蒙大拿州的Sarah Smith在视频中展示,即便在下雪天,雾霾依旧浓重。

马萨诸塞州的居民在灯光下,目睹了如同雨点般飘落的白色雾霾颗粒。更有甚者,佛罗里达的一位居民仅在大雾中停留了10分钟,便开始咳嗽、发烧。
这场突如其来的雾霾,让美国民众心生恐慌。有网友直言:“这难道又是谁在暗中对我们下手?”不禁让人想起那句俗语:“事出反常必有妖。”

回顾历史,1950年的“海洋飞沫行动”让旧金山居民记忆犹新。当时,美国海军进行了一场秘密实验,导致大量民众感染罕见病菌。如今,这场雾霾的出现,让人们不禁联想到那段黑暗历史。
美国国家气象局(NWS)虽然及时发出浓雾警告,但并未能平息民众的疑虑。有人怀疑,这又是一起“海洋飞沫行动”的翻版。然而,气象局解释称,雾霾中的颗粒物源于空气污染物,化学气味则是雾气吸收了地表受污染的空气所致。

尽管气象局表示,这场雾霾只是自然现象,但人们心中的疑虑并未完全消除。毕竟,历史的车轮滚滚向前,谁又能保证过去的悲剧不会重演呢?
这场雾霾,最终在气象局的解释和民众的担忧中渐渐散去。但愿这次真的是一场自然现象,而非人为的灾难。然而,面对未知,人们总是充满恐惧。正如那句名言所说:“恐惧来源于未知,而未知又无处不在。”

在这个充满变数的世界,我们只能提高警惕,时刻关注身边的环境变化。毕竟,生活还要继续,我们不能总是在“迷雾”中前行。这场雾霾的真相,或许永远是个谜,但愿我们的未来,不再被迷雾笼罩。
2026-01-04 06:10:42
2026-01-04 06:08:27
2026-01-04 06:06:13
2026-01-04 06:03:59
2026-01-04 06:01:44
2026-01-04 05:59:30
2026-01-04 05:57:15
2026-01-04 01:30:59
2026-01-04 01:28:45
2026-01-04 01:26:30
2026-01-04 01:24:16
2026-01-04 01:22:02
2026-01-04 01:19:47
2026-01-04 01:17:33
2026-01-04 01:15:19
2026-01-04 01:13:04
2026-01-04 01:10:50
2026-01-04 01:08:36
2026-01-04 01:06:21
2026-01-04 01:04:07